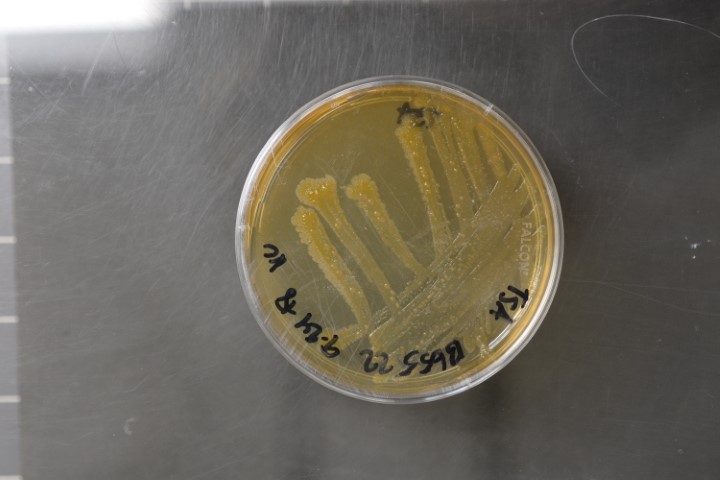

Kalamiella piersonii
NRRL B-65522(Type Strain)
Accession numbers in other collections:IIIF1SW-P2
Source:Dr.Kasthuri Venkateswaran,NASA-JPL-Caltech
Isolated from(substrate):ISS surface wipe
Substrate location:International space station(ISS),US
Growth media:Trypticase Soy Agar(number 15)
Optimum growth temperature:30C
Strain images:
NRRL_B-65522_15.JPG